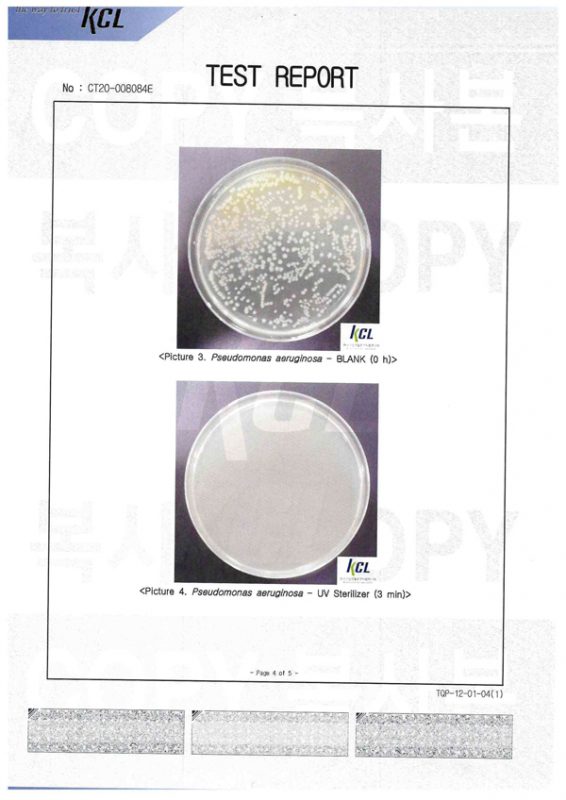
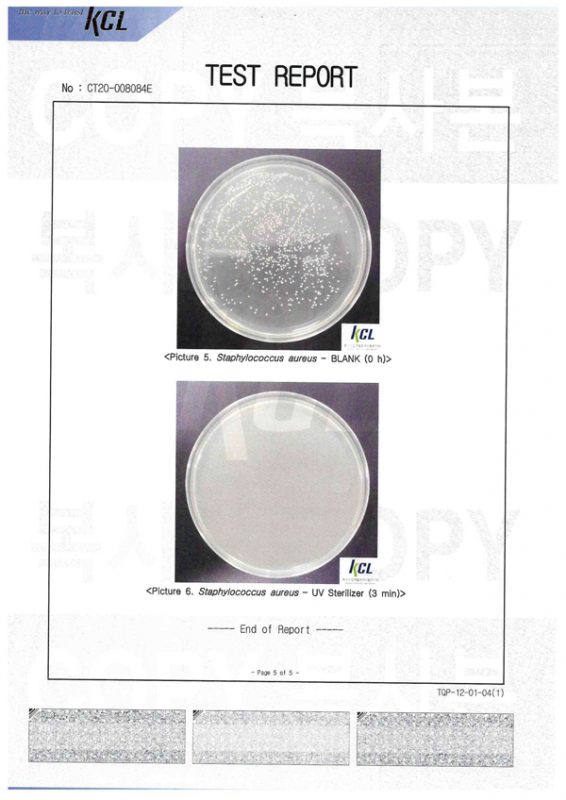

Giải pháp loại bỏ virus, vi khuẩn mà mắt thường không nhìn thấy được một các dễ dàng trong 10 giây ở bất cứ chỗ nào mà bạn cảm thấy không yên tâm
Giá gốc: 2.400.000 đồng/ đèn
KHUYẾN MẠI HẤP DẪN
Chỉ còn 1.699.000 đồng/ đèn
♥ Khử trùng mạnh mẽ hoàn thành trong 10 giây
♥ Kích thước nhỏ gọn dễ dàng mang theo bên mình
♥ Với 13 đèn UV LED kết hợp 2 tia tử ngoại:
♥ Thiết kế dạng trượt phong cách cổ điển và Chức năng bảo vệ mắt